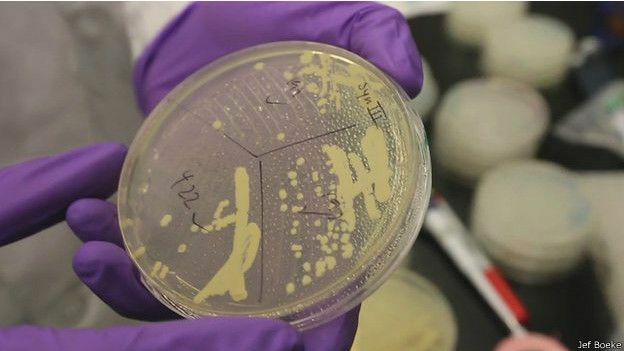
Primer cromosoma sintético de levadura

-

-
 Anton Van Leeuwenhoek , descubrió que la sangre también estaba formada por células y además, descubrió la existencia de microorganismos que denominó "animáculos", formados por una sola célula, las que hoy conocemos como bacterias y protozoos.
Anton Van Leeuwenhoek , descubrió que la sangre también estaba formada por células y además, descubrió la existencia de microorganismos que denominó "animáculos", formados por una sola célula, las que hoy conocemos como bacterias y protozoos. -
 La teoría celular se formula en primer lugar gracias observaciones y formulaciones de Theodor Schwann (fisiólogo) y Matthias Schleiden (botánico). En 1838, Schleiden formuló que todas las plantas están formadas por células, enunciado que su colega Schwann extendió también a los animales llegando así a los dos primeros principios de la actual teoría celular.
La teoría celular se formula en primer lugar gracias observaciones y formulaciones de Theodor Schwann (fisiólogo) y Matthias Schleiden (botánico). En 1838, Schleiden formuló que todas las plantas están formadas por células, enunciado que su colega Schwann extendió también a los animales llegando así a los dos primeros principios de la actual teoría celular. -
 La primera revolución en la Biología con las teorías evolucionistas de Darwin y Wallace, que defendían la universalidad del origen de los seres vivos
La primera revolución en la Biología con las teorías evolucionistas de Darwin y Wallace, que defendían la universalidad del origen de los seres vivos -
 Las leyes de Mendel publicadas por Gregor Mendel, aportan el conjunto de reglas básicas sobre la transmisión por herencia genética de las características de los organismos de padres a sus hijos, y constituyen el fundamento de la genética. Aunque sería hacia 1900 cuando se redescubre a Mendel, sus leyes se trasladan a los humanos y se realizan los primeros estudios en la mosca Leer más: https://www.infosalus.com/salud-investigacion/noticia-10-hitos-genetica-ultimos-150-anos-20160418060434.html
Las leyes de Mendel publicadas por Gregor Mendel, aportan el conjunto de reglas básicas sobre la transmisión por herencia genética de las características de los organismos de padres a sus hijos, y constituyen el fundamento de la genética. Aunque sería hacia 1900 cuando se redescubre a Mendel, sus leyes se trasladan a los humanos y se realizan los primeros estudios en la mosca Leer más: https://www.infosalus.com/salud-investigacion/noticia-10-hitos-genetica-ultimos-150-anos-20160418060434.html -
 A partir del pus de vendajes quirúrgicos y de las células que estaban presentes ahí separo los núcleos y comprobó que en estos había una sustancia química a la que denomino "NUCLEINA"(ÁCIDOS NUCLEICOS).
A partir del pus de vendajes quirúrgicos y de las células que estaban presentes ahí separo los núcleos y comprobó que en estos había una sustancia química a la que denomino "NUCLEINA"(ÁCIDOS NUCLEICOS). -
August Weismann formuló la hoy superada "Teoría del plasma germinal" en 1893: el plasma germinal era la parte nuclear esencial de las células germinales y, a diferencia de las células somáticas (somatoplasma) permanecía cualitativamente idéntica desde el cigoto y era responsable de la herencia.
-
 El análisis de la naturaleza química de los cromosomas generó el descubrimiento del ácido desoxirribonucleico o ADN. En 1926, Phoebus Levene propuso por primera vez un modelo para su conformación: el tetranucleótido plano.
El análisis de la naturaleza química de los cromosomas generó el descubrimiento del ácido desoxirribonucleico o ADN. En 1926, Phoebus Levene propuso por primera vez un modelo para su conformación: el tetranucleótido plano. -
Se constituye una Corporación Científica, de duración indefinida, la que fue fundada en 1928,estara integrada por las personas que deseen pertenecer a ella y sean admitidas en conformidad a estos Estatutos, que por su preparación científica se dediquen al estudio, investigación y difusión de las Ciencias Biológicas en cualquiera de sus ramas.
-
 En 1938 se acuñó por primera vez el termino de biología molecular, enfocándose principalmente al estudio de las macromoléculas. Desde entonces nace la biología molecular como área de conocimiento independiente, tal cual la conocemos hoy.
En 1938 se acuñó por primera vez el termino de biología molecular, enfocándose principalmente al estudio de las macromoléculas. Desde entonces nace la biología molecular como área de conocimiento independiente, tal cual la conocemos hoy. -
 La revista científica Nature publicó un texto en el que los científicos estadounidense James Watson y británico Francis Crick presentaban en sociedad su hallazgo de la estructura molecular en forma de doble hélice del ADN, la molécula portadora del programa genético de los organismos vivo.
La revista científica Nature publicó un texto en el que los científicos estadounidense James Watson y británico Francis Crick presentaban en sociedad su hallazgo de la estructura molecular en forma de doble hélice del ADN, la molécula portadora del programa genético de los organismos vivo.
Dando así inicio a la segunda revolución biológica y a la "universalidad del mecanismo de la información biológica". -
 Un joven investigador francés, describió la causa de la primera enfermedad genética, el síndrome de Down, al descubrir la copia extra del cromosoma 21.
Un joven investigador francés, describió la causa de la primera enfermedad genética, el síndrome de Down, al descubrir la copia extra del cromosoma 21. -
Desarrolló la técnica de difracción de rayos X para aplicarla en la estructura tridimensional de las moléculas orgánicas complejas.
-
 Fue propuesto por los biólogos chilenos Humberto Maturana y Francisco Varela en 1973 para definir la química de automantenimiento de las células vivas. Una descripción breve sería decir que la autopoiesis es la condición de existencia de los seres vivos en la continua producción de sí mismos.
Fue propuesto por los biólogos chilenos Humberto Maturana y Francisco Varela en 1973 para definir la química de automantenimiento de las células vivas. Una descripción breve sería decir que la autopoiesis es la condición de existencia de los seres vivos en la continua producción de sí mismos. -
 Gracias al trabajo conjunto de investigadores de la firma Genentech Inc. en San Francisco, y del centro médico Nacional City of Hope de Los Ángeles, el 6 de septiembre de 1978 se anunció que se había logrado obtener insulina humana a partir de bacterias Escherichia coli.
Gracias al trabajo conjunto de investigadores de la firma Genentech Inc. en San Francisco, y del centro médico Nacional City of Hope de Los Ángeles, el 6 de septiembre de 1978 se anunció que se había logrado obtener insulina humana a partir de bacterias Escherichia coli. -
 E doctor chileno Pablo Valenzuela crea la empresa de biotecnología Chiron Corporation, en California (EE. UU.). Uno de sus trabajos fue el estudio de la genética molecular del virus de la hepatitis B y el desarrollo de tecnología para producir la primera vacuna a nivel mundial contra el mal.
E doctor chileno Pablo Valenzuela crea la empresa de biotecnología Chiron Corporation, en California (EE. UU.). Uno de sus trabajos fue el estudio de la genética molecular del virus de la hepatitis B y el desarrollo de tecnología para producir la primera vacuna a nivel mundial contra el mal. -
 Entre 1985 y 1990 el genetista Kary Mullis y sus colegas desarrollan la técnica de la reacción en cadena de polimerasa (PCR) para ampliar y detectar una secuencia de ADN específica de manera muy rápida in vitro. Leer más: https://www.infosalus.com/salud-investigacion/noticia-10-hitos-genetica-ultimos-150-anos-20160418060434.html
Entre 1985 y 1990 el genetista Kary Mullis y sus colegas desarrollan la técnica de la reacción en cadena de polimerasa (PCR) para ampliar y detectar una secuencia de ADN específica de manera muy rápida in vitro. Leer más: https://www.infosalus.com/salud-investigacion/noticia-10-hitos-genetica-ultimos-150-anos-20160418060434.html -
 Responsable del hallazgo de la ADN polimerasa del virus bacteriófago phi29, su investigación permite a los oncólogos ampliar pequeñas poblaciones de células que podrían dar lugar a tumores y, de esta manera, estudiarlos con más facilidad.
Responsable del hallazgo de la ADN polimerasa del virus bacteriófago phi29, su investigación permite a los oncólogos ampliar pequeñas poblaciones de células que podrían dar lugar a tumores y, de esta manera, estudiarlos con más facilidad. -
 Con el conocimiento del código de instrucciones de cada célula, su estructura y propiedades, en los años 70 fue posible comenzar a manipular dicho código a través de estudios en el laboratorio, como copiar o clonar y secuenciar el material genético o ADN. Se conseguirá realizar la primera clonación de un mamífero a partir de una célula adulta Leer más: https://www.infosalus.com/salud-investigacion/noticia-10-hitos-genetica-ultimos-150-anos-20160418060434.html
Con el conocimiento del código de instrucciones de cada célula, su estructura y propiedades, en los años 70 fue posible comenzar a manipular dicho código a través de estudios en el laboratorio, como copiar o clonar y secuenciar el material genético o ADN. Se conseguirá realizar la primera clonación de un mamífero a partir de una célula adulta Leer más: https://www.infosalus.com/salud-investigacion/noticia-10-hitos-genetica-ultimos-150-anos-20160418060434.html -
Considerada por muchos expertos como el motor de la próxima revolución industrial, esta tecnología tiene aplicaciones múltiples los campos de la electrónica, la biología o la medicina. En este último, las posibilidades son infinitas. En medicina regenerativa, por ejemplo, la idea es conseguir algún día liberar células o pequeños tejidos en órganos enfermos para que éstos puedan ser reparados.
-
 Consorcio internacional formado por científicos de seis países descifraba, dos años antes de lo previsto, la secuencia completa (99,99%) del llamado libro de la vida: el genoma humano. Era la culminación del Proyecto Genoma Humano.
Consorcio internacional formado por científicos de seis países descifraba, dos años antes de lo previsto, la secuencia completa (99,99%) del llamado libro de la vida: el genoma humano. Era la culminación del Proyecto Genoma Humano.
En la larga cadena con forma de hélice que tiene el ADN se ocultan los miles de genes que contienen las instrucciones para el funcionamiento de un ser humano. Un de los logros científicos más influyentes para el desarrollo de las terapias genéticas. -
 Uno de los descubrimientos científicos del siglo XXI más importantes. Desarrollada en 2006 en ratones, la técnica posibilita, que una célula de la piel o de un cabello se convierta en una neurona o en cualquier otro tipo celular. El creador japonés Shinya Yamanaka, recibió en 2012, juntamente con el científico británico John B. Gurdon, el Nobel de Medicina por sus investigaciones pioneras en clonación y células madre. Fuente :descubrimientos-cientificos-del-siglo-xxi/
Uno de los descubrimientos científicos del siglo XXI más importantes. Desarrollada en 2006 en ratones, la técnica posibilita, que una célula de la piel o de un cabello se convierta en una neurona o en cualquier otro tipo celular. El creador japonés Shinya Yamanaka, recibió en 2012, juntamente con el científico británico John B. Gurdon, el Nobel de Medicina por sus investigaciones pioneras en clonación y células madre. Fuente :descubrimientos-cientificos-del-siglo-xxi/ -
La bioquímica australiana y bióloga molecular de la Universidad de Cambridge, además de ganadora del premio ‘Nobel de Medicina y Fisiología’ descubre la telomerasa, enzima que forma los telómetros durante la duplicación del ADN.
-
Craig Venter mostró el primer genoma artificial para una bacteria y asombró al mundo científico.
Craig Venter mostró el primer genoma artificial para una bacteria y asombró al mundo científico. -
 El hallazgo, que sucedió en 2012, permitió comenzar a cambiar el ADN de animales, plantas y microorganismos con una precisión extremadamente alta. Ya se utiliza para nuevas terapias contra el cáncer y se espera que pueda ser de ayuda para curar enfermedades de origen genético.
El hallazgo, que sucedió en 2012, permitió comenzar a cambiar el ADN de animales, plantas y microorganismos con una precisión extremadamente alta. Ya se utiliza para nuevas terapias contra el cáncer y se espera que pueda ser de ayuda para curar enfermedades de origen genético. -
 Doctor chileno del Centro de Biología Integrativa de la Universidad Mayor, cuyo estudio da cuenta de la importancia de una microbiota para la sobrevida de pacientes con cáncer de páncreas.
Doctor chileno del Centro de Biología Integrativa de la Universidad Mayor, cuyo estudio da cuenta de la importancia de una microbiota para la sobrevida de pacientes con cáncer de páncreas. -
 Las vacunas tratan de prevenir la enfermedad provocada por el virus SARS-CoV-2, responsable de la pandemia de enfermedad por coronavirus de 2019-2020. Para febrero de 2021, diez vacunas han sido autorizadas para su uso público por al menos una autoridad reguladora competente, tales como: Tozinamerán de Pfizer-BioNTech, mRNA-1273 de la empresa Moderna, vacunas de coronavirus inactivado, BBIBP-CorV de Sinopharm, BBV152 de Bharat Biotech, CoronaVac de Sinovac, WIBP de Sinopharm, entre otras.
Las vacunas tratan de prevenir la enfermedad provocada por el virus SARS-CoV-2, responsable de la pandemia de enfermedad por coronavirus de 2019-2020. Para febrero de 2021, diez vacunas han sido autorizadas para su uso público por al menos una autoridad reguladora competente, tales como: Tozinamerán de Pfizer-BioNTech, mRNA-1273 de la empresa Moderna, vacunas de coronavirus inactivado, BBIBP-CorV de Sinopharm, BBV152 de Bharat Biotech, CoronaVac de Sinovac, WIBP de Sinopharm, entre otras.
Looking for a timeline maker?
Create timelines for projects, roadmaps, history, lessons, legal cases, and stories with Timetoast. Timetoast is a timeline maker for work, school, research, and stories.


